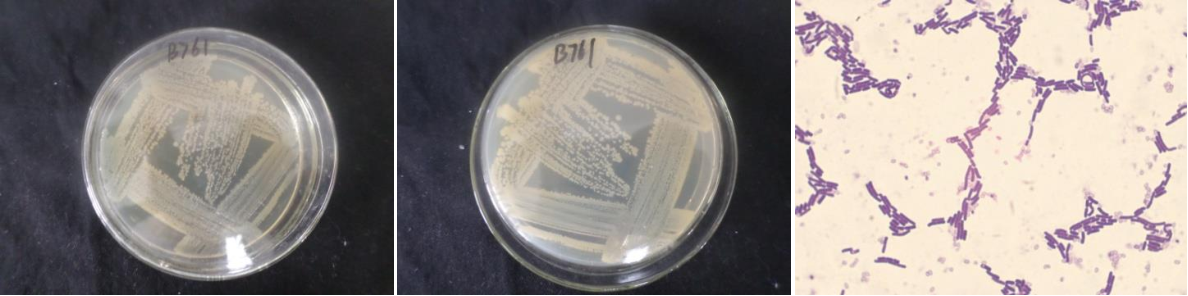

Loading...
| StrainNO | B761 |
| Classification | Bacillus |
| 16s rDNA sequence | CTTCTGGTCCACCTTAGGCGGCTAGCTCCTTACGGTTACTCCACCGACTTCGGGTGTTACAAACTCTCGTGGTGTGACGGGCGG TGTGTACAAGGCCCGGGAACGTATTCACCGCGGCATGCTGATCCGCGATTACTAGCGATTCCAGCTTCATGTAGGCGAGTTGCA GCCTACAATCCGAACTGAGAATGGTTTTATGGGATTGGCTTGACCTCGCGGTCTTGCAGCCCTTTGTACCATCCATTGTAGCAC GTGTGTAGCCCAGGTCATAAGGGGCATGATGATTTGACGTCATCCCCACCTTCCTCCGGTTTGTCACCGGCAGTCACCTTAGAG TGCCCAACTAAATGCTGGCAACTAAGATCAAGGGTTGCGCTCGTTGCGGGACTTAACCCAACATCTCACGACACGAGCTGACGA CAACCATGCACCACCTGTCACTCTGTCCCCCGAAGGGGAACGCTCTATCTCTAGAGTTGTCAGAGGATGTCAAGACCTGGTAAG GTTCTTCGCGTTGCTTCGAATTAAACCACATGCTCCACCGCTTGTGCGGGCCCCCGTCaAATTCCTTTGAGTTTCAGTCTTGCG ACCGTACWCCCCAGGCGGAGTGCTTAATGCGTTAGCTGCAGCACTAAAGGGCGGAAACCCTCTAACACTTAGCACTCATCGTTT ACGGCGTGGACTACCAGGGTATCTAATCCTGTTTGCTCCCCACGCTTTCGCGCCTCAGCGTCAGTTACAGACCAAAAAGCCGCC TTCGCCACTGGTGTTCCTCCACATCTCTACGCATTTCACCGCTACACGTGGAATTCCGCTTTTCTCTTCTGCACTCAAGTTCCCCAGTTTCCAATGACCCTCCACGGTTGAGCCGTGGGCTTTCACATCAGACTTAAGAAACCGCCTGCGCGCGCTTTACGCCCAATA ATTCCGGATAACGCTTGCCACCTACGTATTACCGCGGCTGCTGGCACGTAGTTAGCCGTGGCTTTCTGGTTAGGTACCGTCAAG GTACAAGCAGTTACTCTCGTACTTGTTCTTCCCTAACAACAGAGTTTTACGACCCGAAAGCCTTCATCACTCACGCGGCGTTGC TCCGTCAGACTTTCGTCCATTGCGGAAGATTCCCTACTGCTGCCTCCCGTAGGAGTCTGGGCCGTGTCTCAGTCCCAGTGTGGC CGATCACCCTCTCAGGTCGGCTATGCATCGTTGCCTTGGTGAGCCGTTACCTCACCAACTAGCTAATGCACCGCGGGCCCATCT GTAAGTGATAGCCGAAACCATCTTTCAATCATCTCCCATGAAGGAGAAGATCCTATCCGGTATTAGCTTCGGTTTCCCGAAGTT ATCCCAGTCTTACAGGCAGGTTGCCCACGTGTTACTCACCCGTCCGCCGCTAACGTCATAGAAGCAAGCTTCTAATCAGTTCGC TCGACTTGCATGTATTAGCACGCCGCCAG |
| Strain Morphology Photos | |
| Morphological Description | The morphology of Colony round;lychee white;edge serrated;edge bumps;convex in the middle;slippy;sticky;waxy;The morphology of strain:Rod;having spore;bias in budding spores |